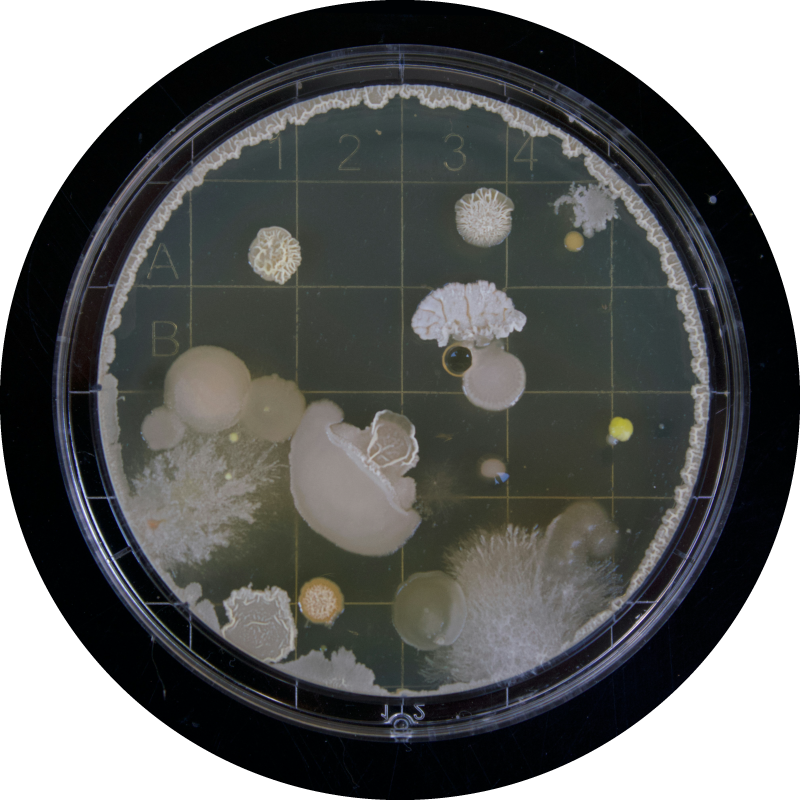
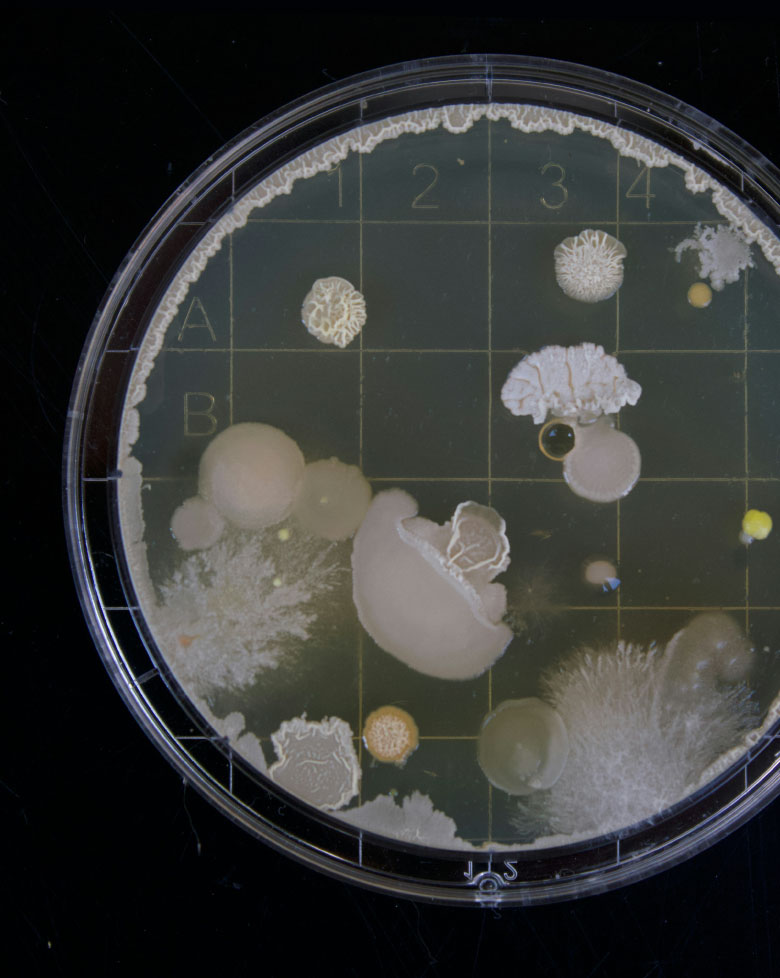

Μικροβιολογικό Τμήμα
Στο Μικροβιολογικό Εργαστήριο της Ευρωδιάγνωσης Κέρκυρας, η ακρίβεια και η αξιοπιστία των αποτελεσμάτων μας είναι προτεραιότητα.
Στο Μικροβιολογικό Εργαστήριο της Ευρωδιάγνωσης Κέρκυρας, η ακρίβεια και η αξιοπιστία των αποτελεσμάτων μας είναι προτεραιότητα. Με σύγχρονο εξοπλισμό, αυστηρά πρωτόκολλα ποιότητας και εξειδικευμένους επιστήμονες, αλλά και έμπειρους επαγγελματίες υγείας, παρέχουμε ολοκληρωμένες διαγνωστικές υπηρεσίες που βοηθούν στη σωστή και έγκαιρη διάγνωση.
Στο Μικροβιολογικό Εργαστήριο της Ευρωδιάγνωσης Κέρκυρας, διενεργείται όλο το φάσμα των εργαστηριακών εξετάσεων, από τις εξετάσεις ρουτίνας έως τον πλήρη εξειδικευμένο έλεγχο καλύπτοντας κάθε ανάγκη.
Οι Υπηρεσίες μας:
- Μικροβιολογικές εξετάσεις – Καλλιέργειες βιολογικών υγρών
- Αιματολογικές εξετάσεις
- Βιοχημικές αναλύσεις
- Ορμονολογικές εξετάσεις
- Ανοσολογικές & Ορολογικές εξετάσεις
- Τοξικολογικές εξετάσεις
Μοριακή διαγνωστική (PCR & γενετικοί έλεγχοι)
-
Ανίχνευση αναπνευστικών ιών (COVID-19, RSV, γρίπη)
-
Ανίχνευση και τυποποίηση HPV- DNA
-
Έλεγχος Θρομβοφιλίας
-
Έλεγχος Κυστικής Ίνωσης (CFTR)
-
Αντιγόνο Ιστοσυμβατότητας (HLA-B27)
-
Ανίχνευση HBV & HCV
-
Το Εργαστήριο Ευρωδιάγνωση Κέρκυρας, επεκτείνοντας το αντικείμενο των παρεχόμενων υπηρεσιών του, έχει εντάξει και ειδικές εξετάσεις όπως ανάλυση τεστ αναπνοής για την διάγνωση της λοίμωξης απο Ελικοβακτηρίδιο του Πυλωρού (HelicobacterPylori).

8η πάροδος Ιωάννη Θεοτόκη, ΤΚ 491 32, Κέρκυρα.
Η Ευρωδιάγνωση Κέρκυρας προσφέρει μια σειρά από δράσεις και υπηρεσίες για την προαγωγή της υγείας και την έγκαιρη διάγνωση:
- Ειδικά πακέτα check-up προσαρμοσμένα για παιδιά και ενήλικες, καλύπτοντας βασικές και εξειδικευμένες εξετάσεις.
- Ειδικές τιμές και προσφορές σε σημαντικές παγκόσμιες ημέρες υγείας, με σκοπό την ευαισθητοποίηση και τη διευκόλυνση της πρόσβασης σε προληπτικές εξετάσεις.
- Συνεργασία με το πρόγραμμα «Προλαμβάνω» του κράτους, που παρέχει δωρεάν ή επιδοτούμενους προληπτικούς ελέγχους για μαστό και καρδιαγγειακά νοσήματα και σε ό,τι νέο προκύψει στο πλαίσιο των κρατικών προγραμμάτων πρόληψης.
Μέσα από αυτές τις δράσεις, η Ευρωδιάγνωση Κέρκυρας διαμορφώνει ένα ολοκληρωμένο πλαίσιο προληπτικής φροντίδας, συμβάλλοντας ουσιαστικά στην έγκαιρη διάγνωση και αποτελεσματική θεραπεία.






